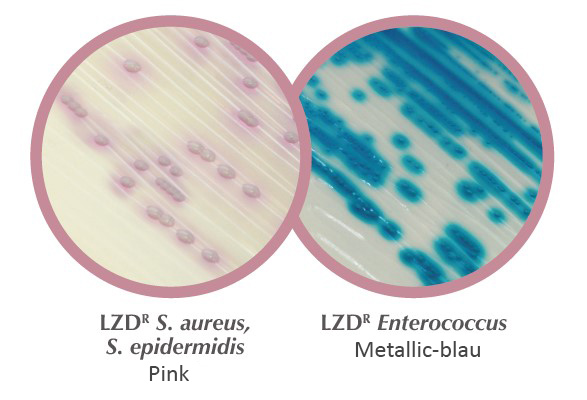

Entdecken Sie unser chromogenes Medium: CHROMagar™ LIN-R
Chromogenes Nährmedium zum Nachweis und zur Differenzierung Linezolid-resistenter grampositiver Bakterien.
Grampositive Kokken stellen aufgrund ihrer Antibiotikaresistenzen eine globale Bedrohung für die menschliche Gesundheit dar. Linezolid besitzt ein breites Wirkspektrum gegen verschiedene grampositive pathogene Mikroorganismen, wie MRSA, VRS und VRE. Seit Zulassung der klinischen Anwendung von Linezolid wird zunehmend das Auftreten Linezolid-resistenter Stämme (LIN-R) sowie einer horizontalen Ausbreitung der Resistenz in Verbindung mit dem cfr-Gen beobachtet.
Obwohl die Prävalenz der Linezolid-Resistenz nach wie vor gering ist, gibt das Auftreten von LIN-R-Stämmen Anlass zur Sorge. Die Sensibilität grampositiver Kokken in klinischen Proben gegenüber Linezolid wird heute hauptsächlich durch Monitoringprogramme in Europa und den USA erfasst. Zu den klinischen Proben zwecks Monitoring Linezolid-resistenter Stämmen zählen Nasenabstriche (Nachweis von Staphylokokken) sowie perianale und rektale Abstriche (Nachweis von Enterokokken).
Vorteile des CHROMagar™ LIN-R:
- Sehr sensitiv: Nachweis der MHK bis zu 8 µg/mL
- Direkt aus dem Probenmaterial
- Die Identifizierung mittels MALDI-TOF kann direkt mit einer Kolonie von der Platte durchgeführt werden.
- Für erfahrene Anwender ist die Differenzierung zwischen E. faecium und E. faecalis, sowie zwischen S. aureus und S. epidermidis mit dem bloßen Auge möglich.
- Spezifität: 100 %, Sensitivität: 99 %
Den CHROMagar™ LIN-R erhalten Sie bei uns in folgenden Varianten:
CHROMagar™ LIN-R Fertigplatten
(gebrauchsfertige Platten, 20 Stück, Art. Nr. 201476)
CHROMagar™ LIN-R Trockennährmedium
(5 Liter, Art. Nr. 15LN762)
